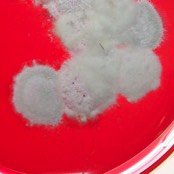

Tierärztliche Leistungen in der Praxis

Leistungen:
Osteopathie, hierin inbegriffen neurologische und innere Organuntersuchungen

Impfungen und Wurmkuren (Kotuntersuchungen) mit kritischer Sichtweise

Allergiediagnostik mit entsprechender Desensibilisierung und Fütterungsberatung
Zahnsteinentfernung mit Ultraschall
Parasitendiagnostik und Behandlung





Sachkundenachweis nach Hundeverordnung (s. Link unten)
Kennzeichnung mit Chip und Registrierung bei TASSO (bei uns automatisch!)
Auf eines können Sie sich aber verlassen: ich kann nicht alles wissen, dann werden Sie mit Ihrem Liebling aber zu jemanden geschickt, der sich damit auskennt.
Tierarztpraxis Gregor Leist
Honnendorp 58
47906 Kempen
Tel.: +49(0)2152 / 897345
Fax.: +49(0)2152 / 897346
Email: contact@tierarztpraxis-leist.de
URL.: www.tierarztpraxis-leist.de
Termine nur nach Vereinbarung
keine freie Sprechstunde
Telefonische Erreichbarkeit:
Mo, Di, Do, Fr 8-12 Uhr und 14-18 Uhr
Mittwochs 15-18 Uhr
In dringenden Notfällen nutzen Sie bitte die Ihnen bekannte Handynummer.
Honnendorp 58
47906 Kempen
Tel.: +49(0)2152 / 897345
Fax.: +49(0)2152 / 897346
Email: contact@tierarztpraxis-leist.de
URL.: www.tierarztpraxis-leist.de
Termine nur nach Vereinbarung
keine freie Sprechstunde
Telefonische Erreichbarkeit:
Mo, Di, Do, Fr 8-12 Uhr und 14-18 Uhr
Mittwochs 15-18 Uhr
In dringenden Notfällen nutzen Sie bitte die Ihnen bekannte Handynummer.